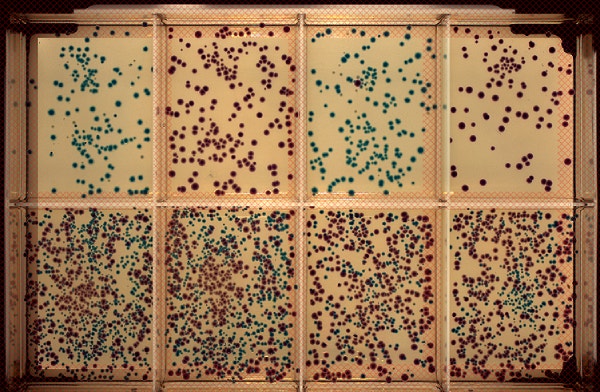

Microbiomes
Accelerate culturomics with precision and sterility
Isolate hard-to-culture anaerobes with confidence. QPix FLEX enables automated colony picking, plating, and liquid handling – even inside hypoxic chambers – supporting reproducible, contamination-free workflows for microbiome discovery, probiotic development, and gut-brain axis research.